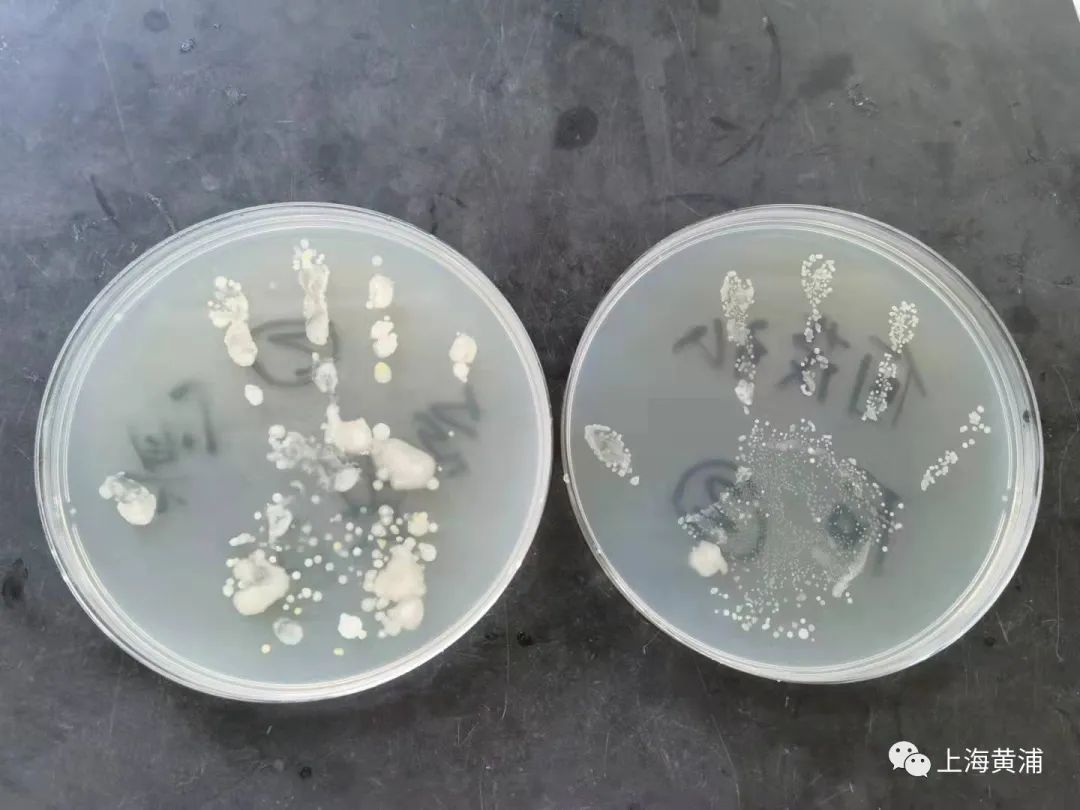

一双萌萌的小手看似干净,其实真的卫生吗?在9月24日上午举行的黄浦区“小习惯、大健康”洗手宣传周启动仪式上,萌娃们在老师的带领下,唱起“洗手歌”,跳着“洗手舞”,以寓教于乐的方式,学习正确的洗手方法,倡导正确洗手、健康生活的理念。

10月15日是世界洗手日,记者了解到,黄浦区疾控中心将携手区域内各托幼机构、托育园开展“小习惯,大健康”洗手宣传周活动,通过“看一看”——观看《小手有点脏,怎样洗干净?》科普视频,“读一读”——翻阅《小习惯 大健康》科普绘本,“听一听”——听老师上一堂如何正确洗手的科普课,以及每天和爸爸妈妈完成洗手“打卡”等丰富的活动,对幼儿开展手卫生科普教育,帮助他们养成良好卫生习惯和健康生活方式。

记者在现场看到,小朋友们在黄浦区疾控中心专业人员的指导下,先用小小的脏手在培养皿上按压,并在规范洗手后再次按压,并由疾控中心的叔叔阿姨带回实验室“培养”,将洗手前后的细菌对比图展示给小朋友们,告诉他们“看似干净的小手其实暗藏许多细菌”,从而增强他们勤洗手的健康意识。

记者获悉,在宣传周期间,我区各托幼机构、托育园将开展形式多样的幼儿手卫生宣传教育活动。
记者 / 王菁
编辑 / 黄骞文
图片 / 蔡维帅